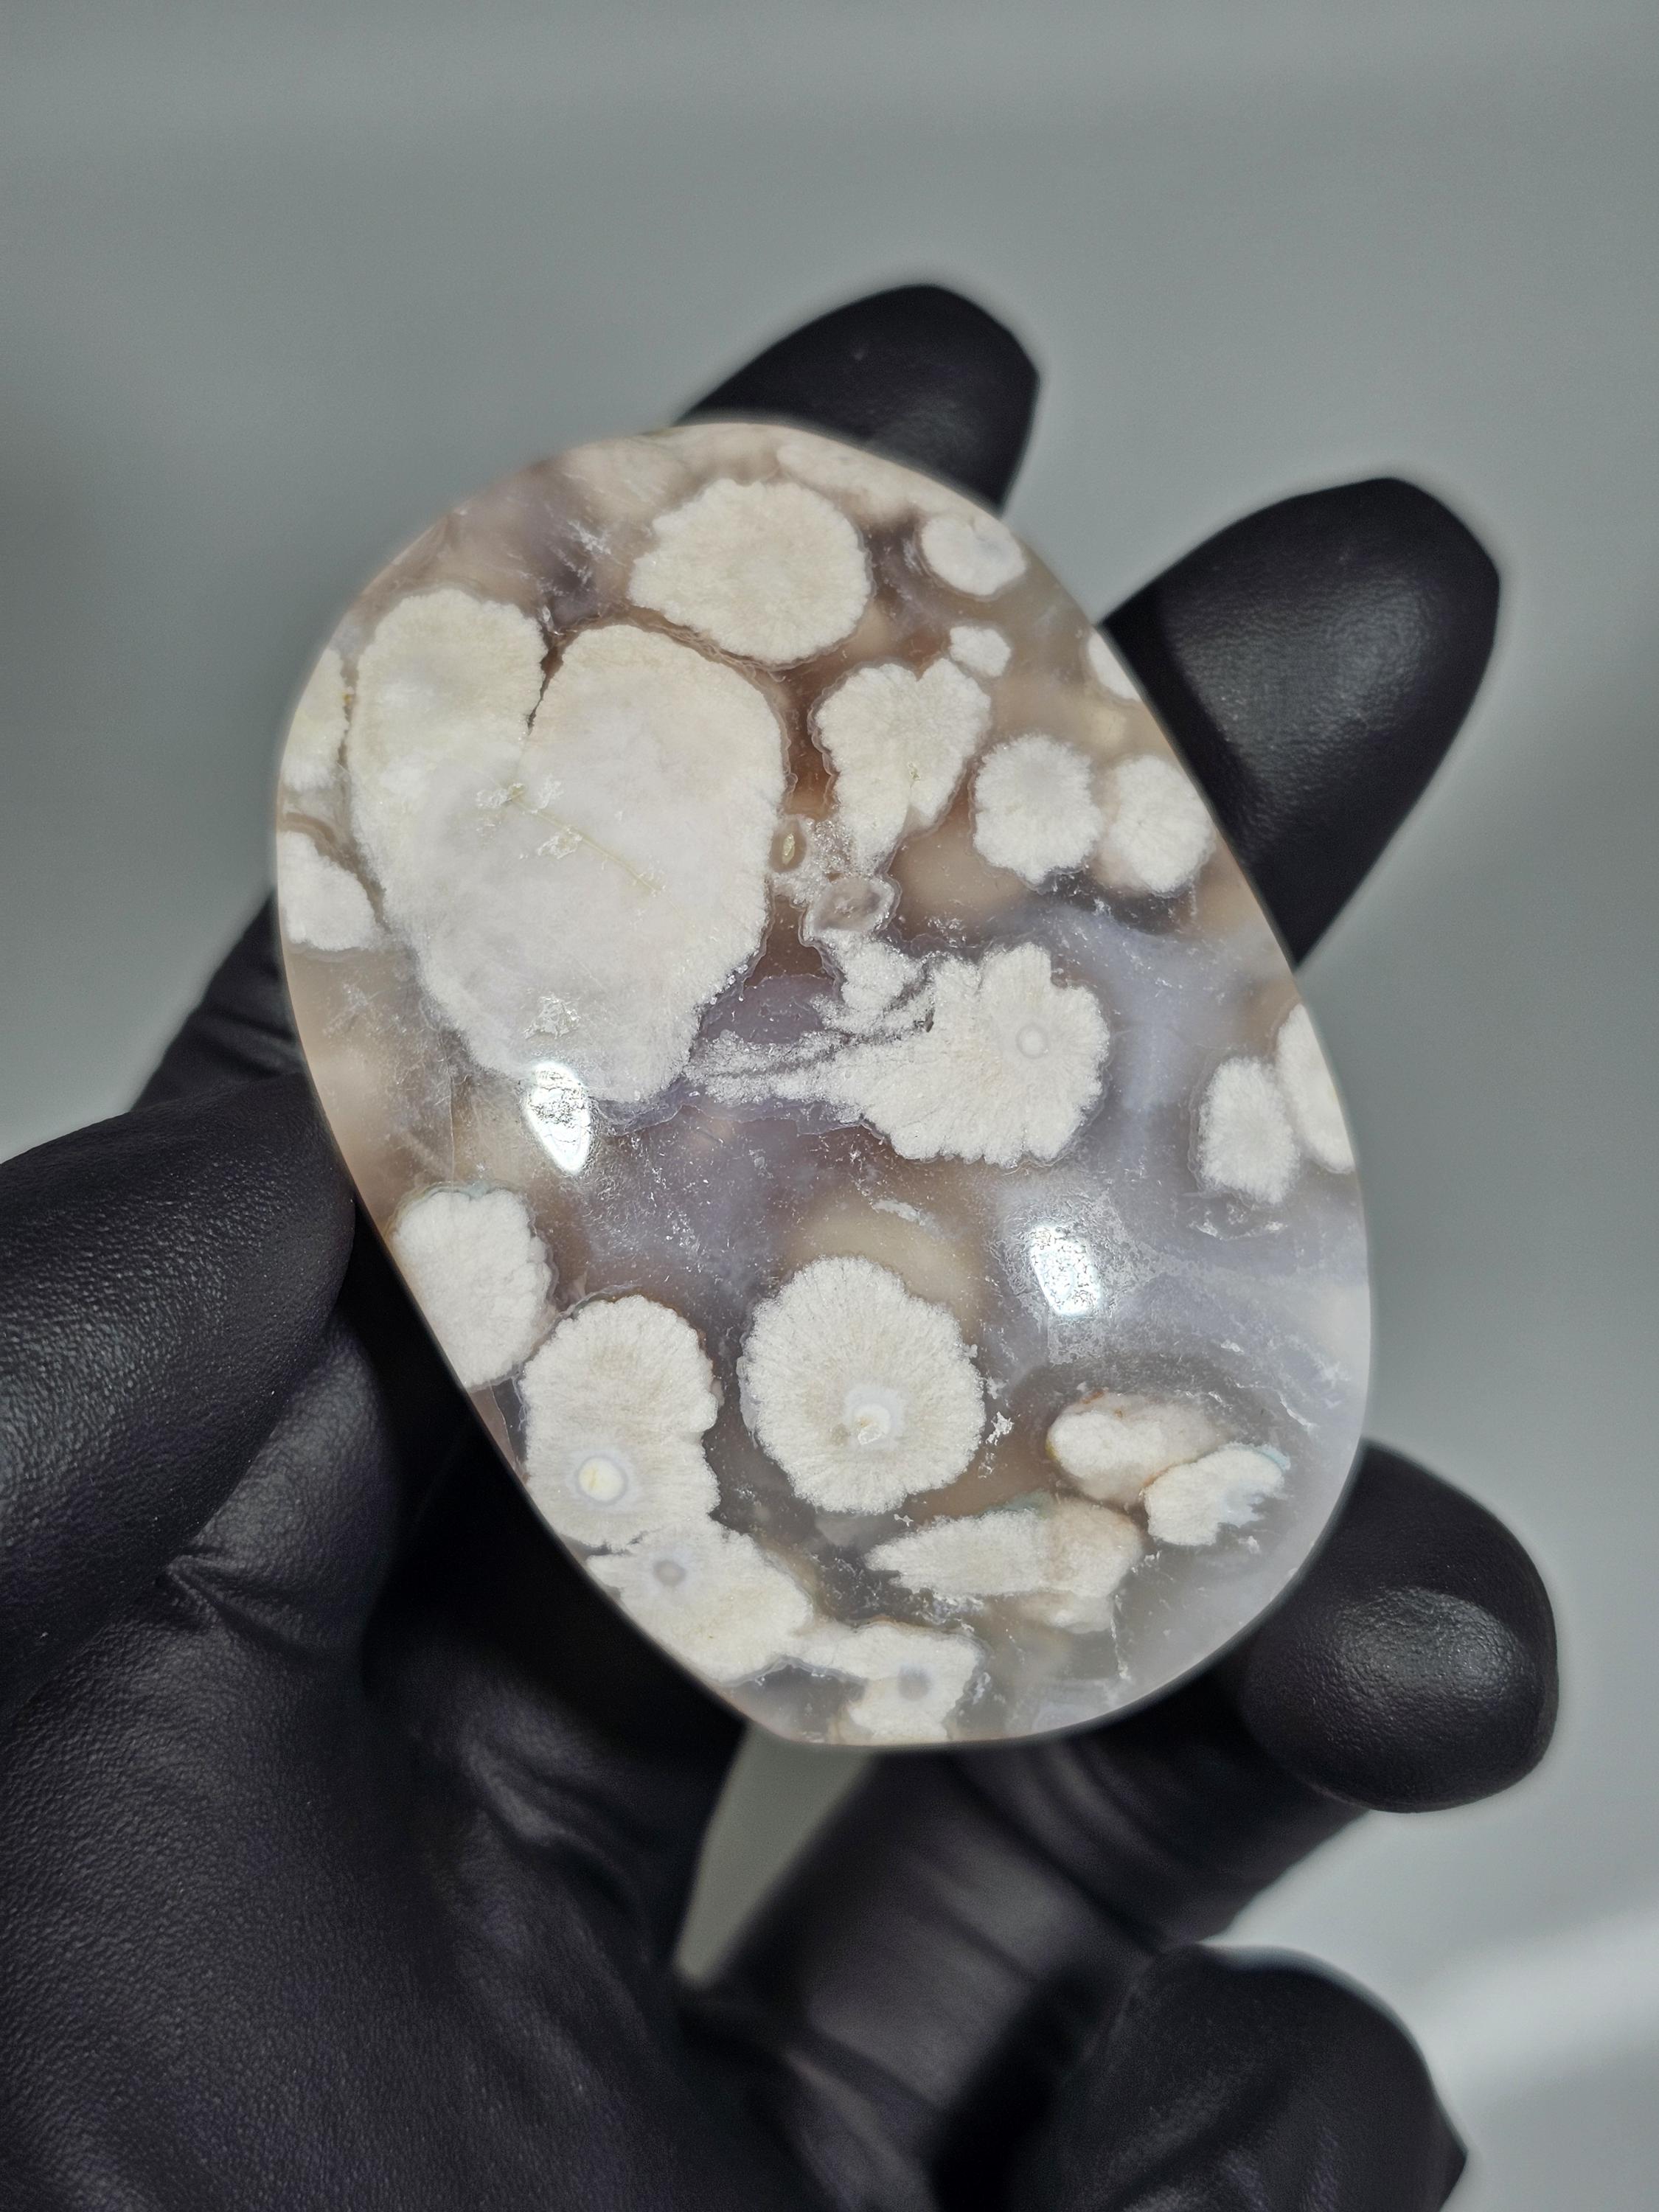
gallery photo

Cherry Flower Agate Palm Stone

$12.00 $16.00
Cherry flower agate palm stone. Measures approximately 2.11" x 1.43" x .62"
***has natural imperfection
You will receive the exact item pictured.
Need more photos or video? Message me and I'll respond as soon as possible! Please note: All photographs are taken with professional photography lighting to show the best detail possible. There is no editing to these photos to enhance how items look. (only cropping or numbering) Colors may vary slightly from what is shown. I do my best to accurately represent each piece available.
Shipping from United States
Processing time
2-3 business days
Payment Options
Returns & Exchanges
Returns & exchanges not accepted
But please contact me if you have problems with your order
